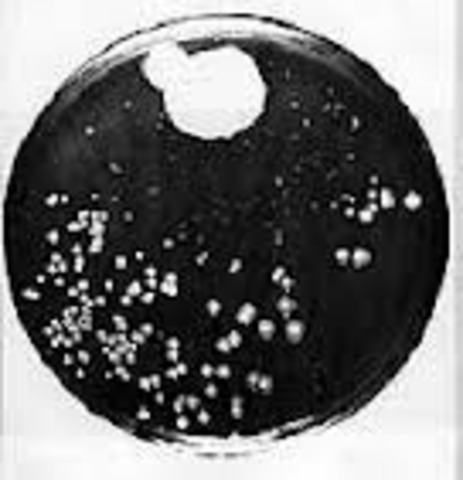
Penicillium Notatum

-
Alexander fleming was born on the 6th of August, 1881 in Louchfield. His parents are called Hugh Fleming (father) and Grace Stirling Morton (mother).
-
Alexander Fleming was educated in Kilmarnock Academy in round about 1900. Then he went to University of Westminster and then graduated in Imperial College London.
-
Alexander Fleming discovered lysozome which is a enzyme that is found in sweat and tear naturally. The enzyme has a antibacterial effect it is not able to defeat the strongest of infections. He was very excited about his latest discovery that it has cause a lot of mess in his lab because of how busy he was.
-
In 1928, he was tidying his lab. Then he found his pile of petri dishes that has and contain bateria in then because he forgotten to clean them. He decided to take a look at them instead of cleaning them. He has found out that the bateria he had been growing were dead.
-
When checking his dishes, he found a mould on it and wondered if it was called Penicillium notatum (substance that kills bateria), so he tested his prediction. After testing, he thinks that his prediction must be correct.
-
In 1945, Sir Alexander Fleming, Ernst Boris Chain and Sie Howard Walter Florey was awarded the nobel prize in Physiology or Medicine. "for the discovery of penicillin and its curative effect in various infectious diseases".
-
Alexander died on 11th of March, 1955 in London.
Want to make a timeline like this?
Use Timetoast to turn dates, events, milestones, and phases into a clear visual timeline you can build and share. Timetoast is a timeline maker for work, school, research, and stories.